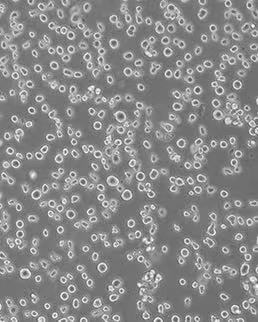
新闻图片2

武汉尚恩生物技术有限公司品牌商
6 年
手机商铺
商家活跃:
产品热度:
- NaN
- 0.2999999999999998
- 0.2999999999999998
- 2.3
- 2.3
重组人粒细胞-巨噬细胞刺激因子rhGM-CSF
¥750
推荐产品
公司新闻/正文
TF-1细胞中为什么要加刺激因子GM-CSF?
669 人阅读发布时间:2023-02-07 08:55
细 胞 基 本 信 息
细胞名称:TF-1(人红白血病细胞)
细胞别称:TF1; MFD-1
细胞货号:SNL-222
生长特性:悬浮
培养条件:1640+10% FBS+2ng/mL GM-CSF+1% P/S
培养环境:空气,95%;二氧化碳 (CO2),5%
细胞简介:TF-1细胞是由Kitamura·T等人于1987年建立,源于一名35岁日本男性的肝素化骨髓抽取样本,该患者具有严重的全血细胞减少症。TF-1细胞生长完全依赖于IL-3或GM-CSF,对IL-5无反应。多种淋巴因子和细胞因子对TF-1细胞都有作用,如:IL-1、IL-4、IL-6、IL-9、IL-11、IL-13、CSF、LIF、NGF。TF-1细胞不表达血型糖蛋白A和~酶I。细胞的形态和细胞化学特征及珠蛋白基因的持续表达,显示TF-1细胞属于红系。血红素和δ-氨基乙酰~诱导TF-1细胞血红蛋白合成,TPA诱导TF-1细胞显著分化为巨噬细胞样细胞。TF-1细胞为研究髓系祖细胞的增殖和分化提供了良好的系统。
细胞正常生长形态照片


1、人红白血病细胞X40 2、人红白血病细胞X100

1、人红白血病细胞X40 2、人红白血病细胞X100
操 作 实 例
提问
TF-1细胞中刺激因子GM-CSF添加浓度为2ng/mL,如果不加刺激因子对细胞有什么影响?是必须要添加吗?
回答
必须添加。不添加GM-CSF培养,TF-1细胞会在传2-3代或冻存重新复苏后出现细胞生长速度严重下降,甚至不生长。培养过程会有部分细胞死亡,产生较多细胞碎片。
注 意 事 项
细胞需添加GM-CSF培养,否则细胞状态将变差至无法增殖;建议购买配套的完全培养基培养该细胞。
产品推荐
【SNL-222】TF-1(人红白血病细胞)
【SNLM-222】人红白血病细胞专用培养基
【SNCF-002】重组人粒细胞-巨噬细胞刺激因子rhGM-CSF



